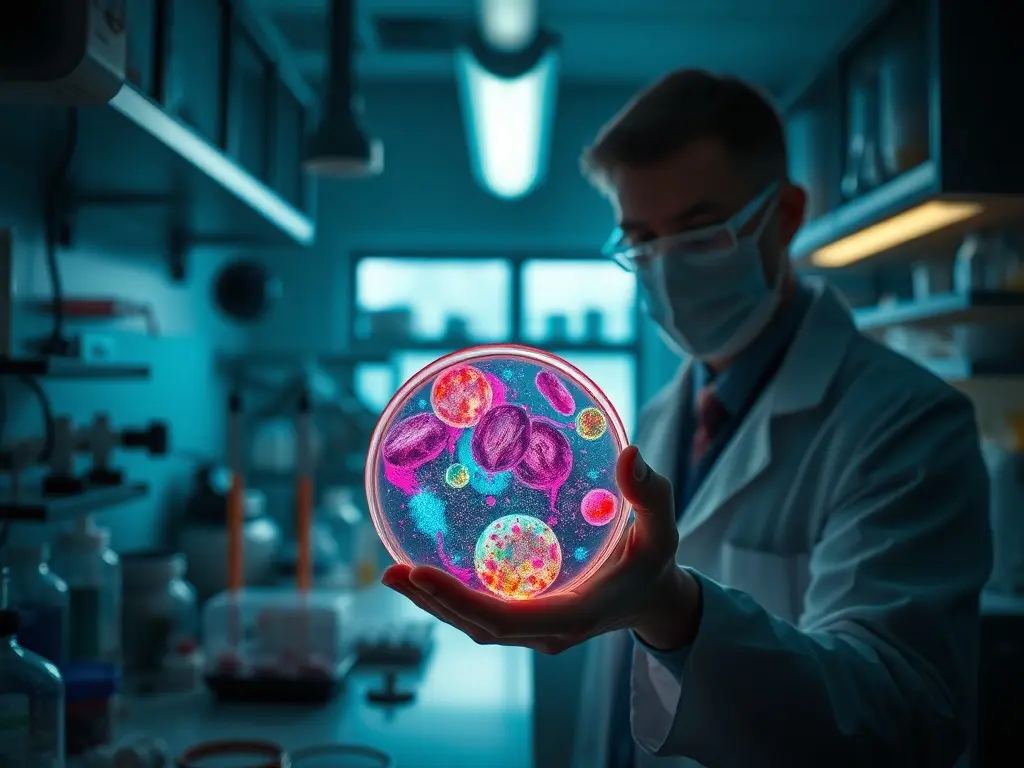
Trump's order is a milestone for proponents of using psychedelics as medicine

Trump's order is a milestone for proponents of using psychedelics as medicine
President Trump signed an executive order to accelerate research and approval of psychedelics for treating mental health conditions. The order aims to speed up the study of psychedelics for conditions like depression, PTSD, and addiction.
President Trump has signed an executive order to accelerate research and approval of psychedelics for treating mental health conditions. The order aims to speed up the study of psychedelics for conditions like depression, PTSD, and addiction. Psychedelics have been gaining attention for their potential therapeutic benefits. The executive order is seen as a milestone for proponents of using psychedelics as medicine. It is expected to boost research into the therapeutic potential of psychedelics.
This content was automatically generated and/or translated by AI. It may contain inaccuracies. Please refer to the original sources for verification.